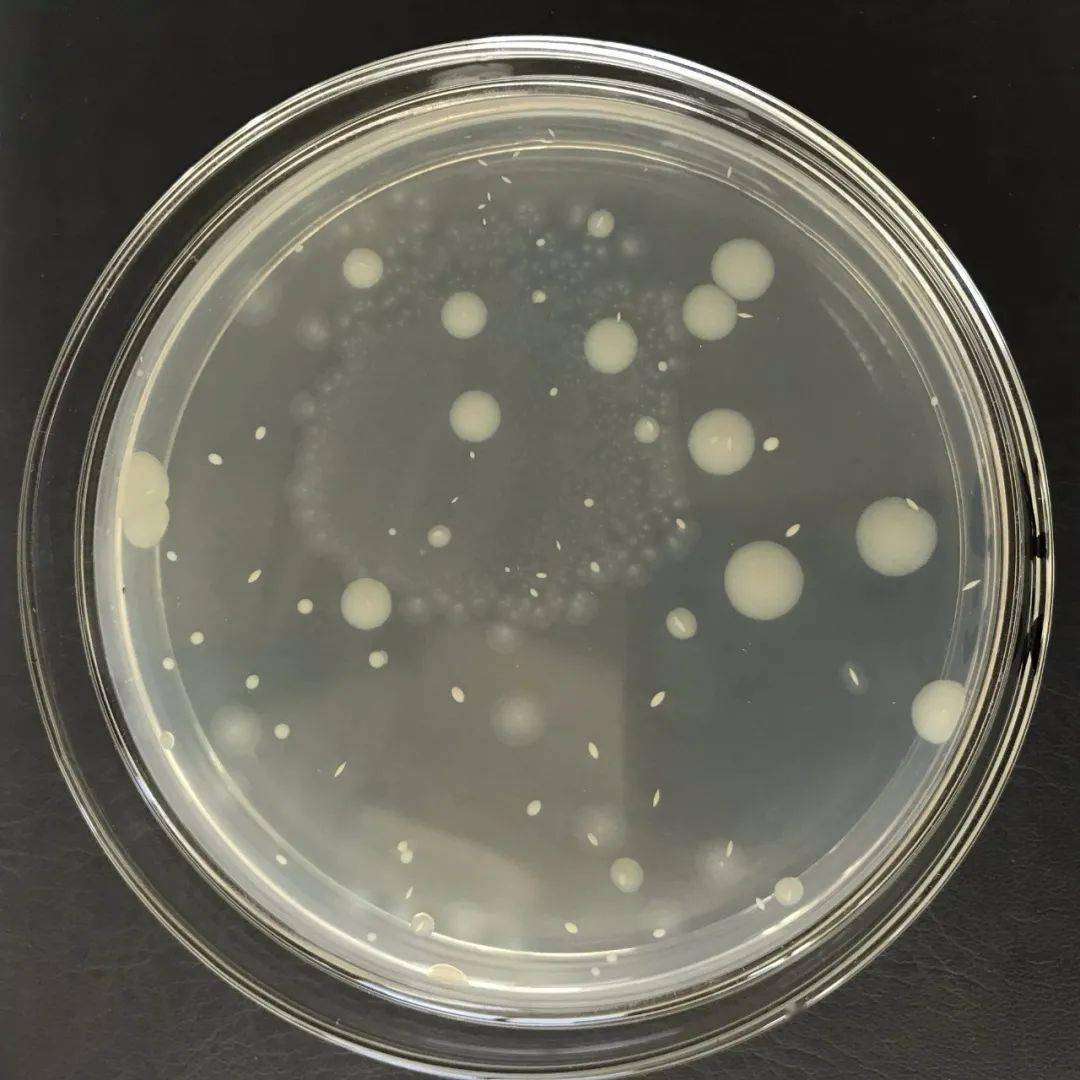
快自查菌落总数的错误操作你中招了没
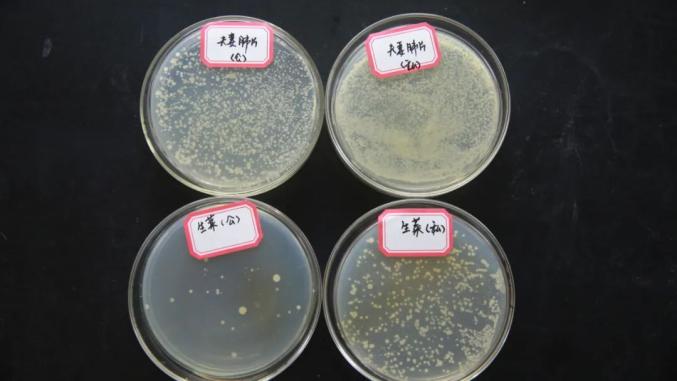
实验结果显示,不使用公筷菌落总数是使用公筷的15到20倍左右.

菌落总数

(肉眼可见,菌落总数在储存12小时和24小时后逐渐递增,在24小时候菌落
图片尺寸600x450
菌落总数实物图片!
图片尺寸1280x960
表表26—1 计算菌数落总数方法举例
图片尺寸937x459
效率高能耗低灭菌,洗净后菌落总数小于10
图片尺寸1626x760
常见微生物菌落形态图比较总结(菌落总数不合格原因与对策)#微 - 抖音
图片尺寸1440x1426
菌落总数.jpg
图片尺寸1241x1755
菌落总数计数
图片尺寸744x992
ascari菌落总数测试片餐饮水质微生物检验过期腐败细菌检测筛查常
图片尺寸800x800
快自查菌落总数的错误操作你中招了没
图片尺寸1080x1080
菌落总数检测结果
图片尺寸3024x4032
益生菌的菌落总数
图片尺寸1221x563
表10-1 计算细菌菌落总数方法的示例菌落计数报告,菌落数在100以内按
图片尺寸1760x656
精华菌落总数检测技术要点
图片尺寸1058x630
菌落总数5个平行样品
图片尺寸700x284
实验结果显示,不使用公筷菌落总数是使用公筷的15到20倍左右.
图片尺寸677x381
菌落总数
图片尺寸864x286
检测方法 化妆品中菌落总数检验方法
图片尺寸570x256
隔夜西瓜一口8400个细菌菌落总数达42000还能吃吗关键看这几点
图片尺寸850x283
表1 大肠杆菌菌落,金黄色葡萄球菌菌落,白色念珠菌菌落总数随时间变化
图片尺寸518x205
菌落总数作为微生物检测中最常见的项目,在检验的每一个环节都应该
图片尺寸776x448